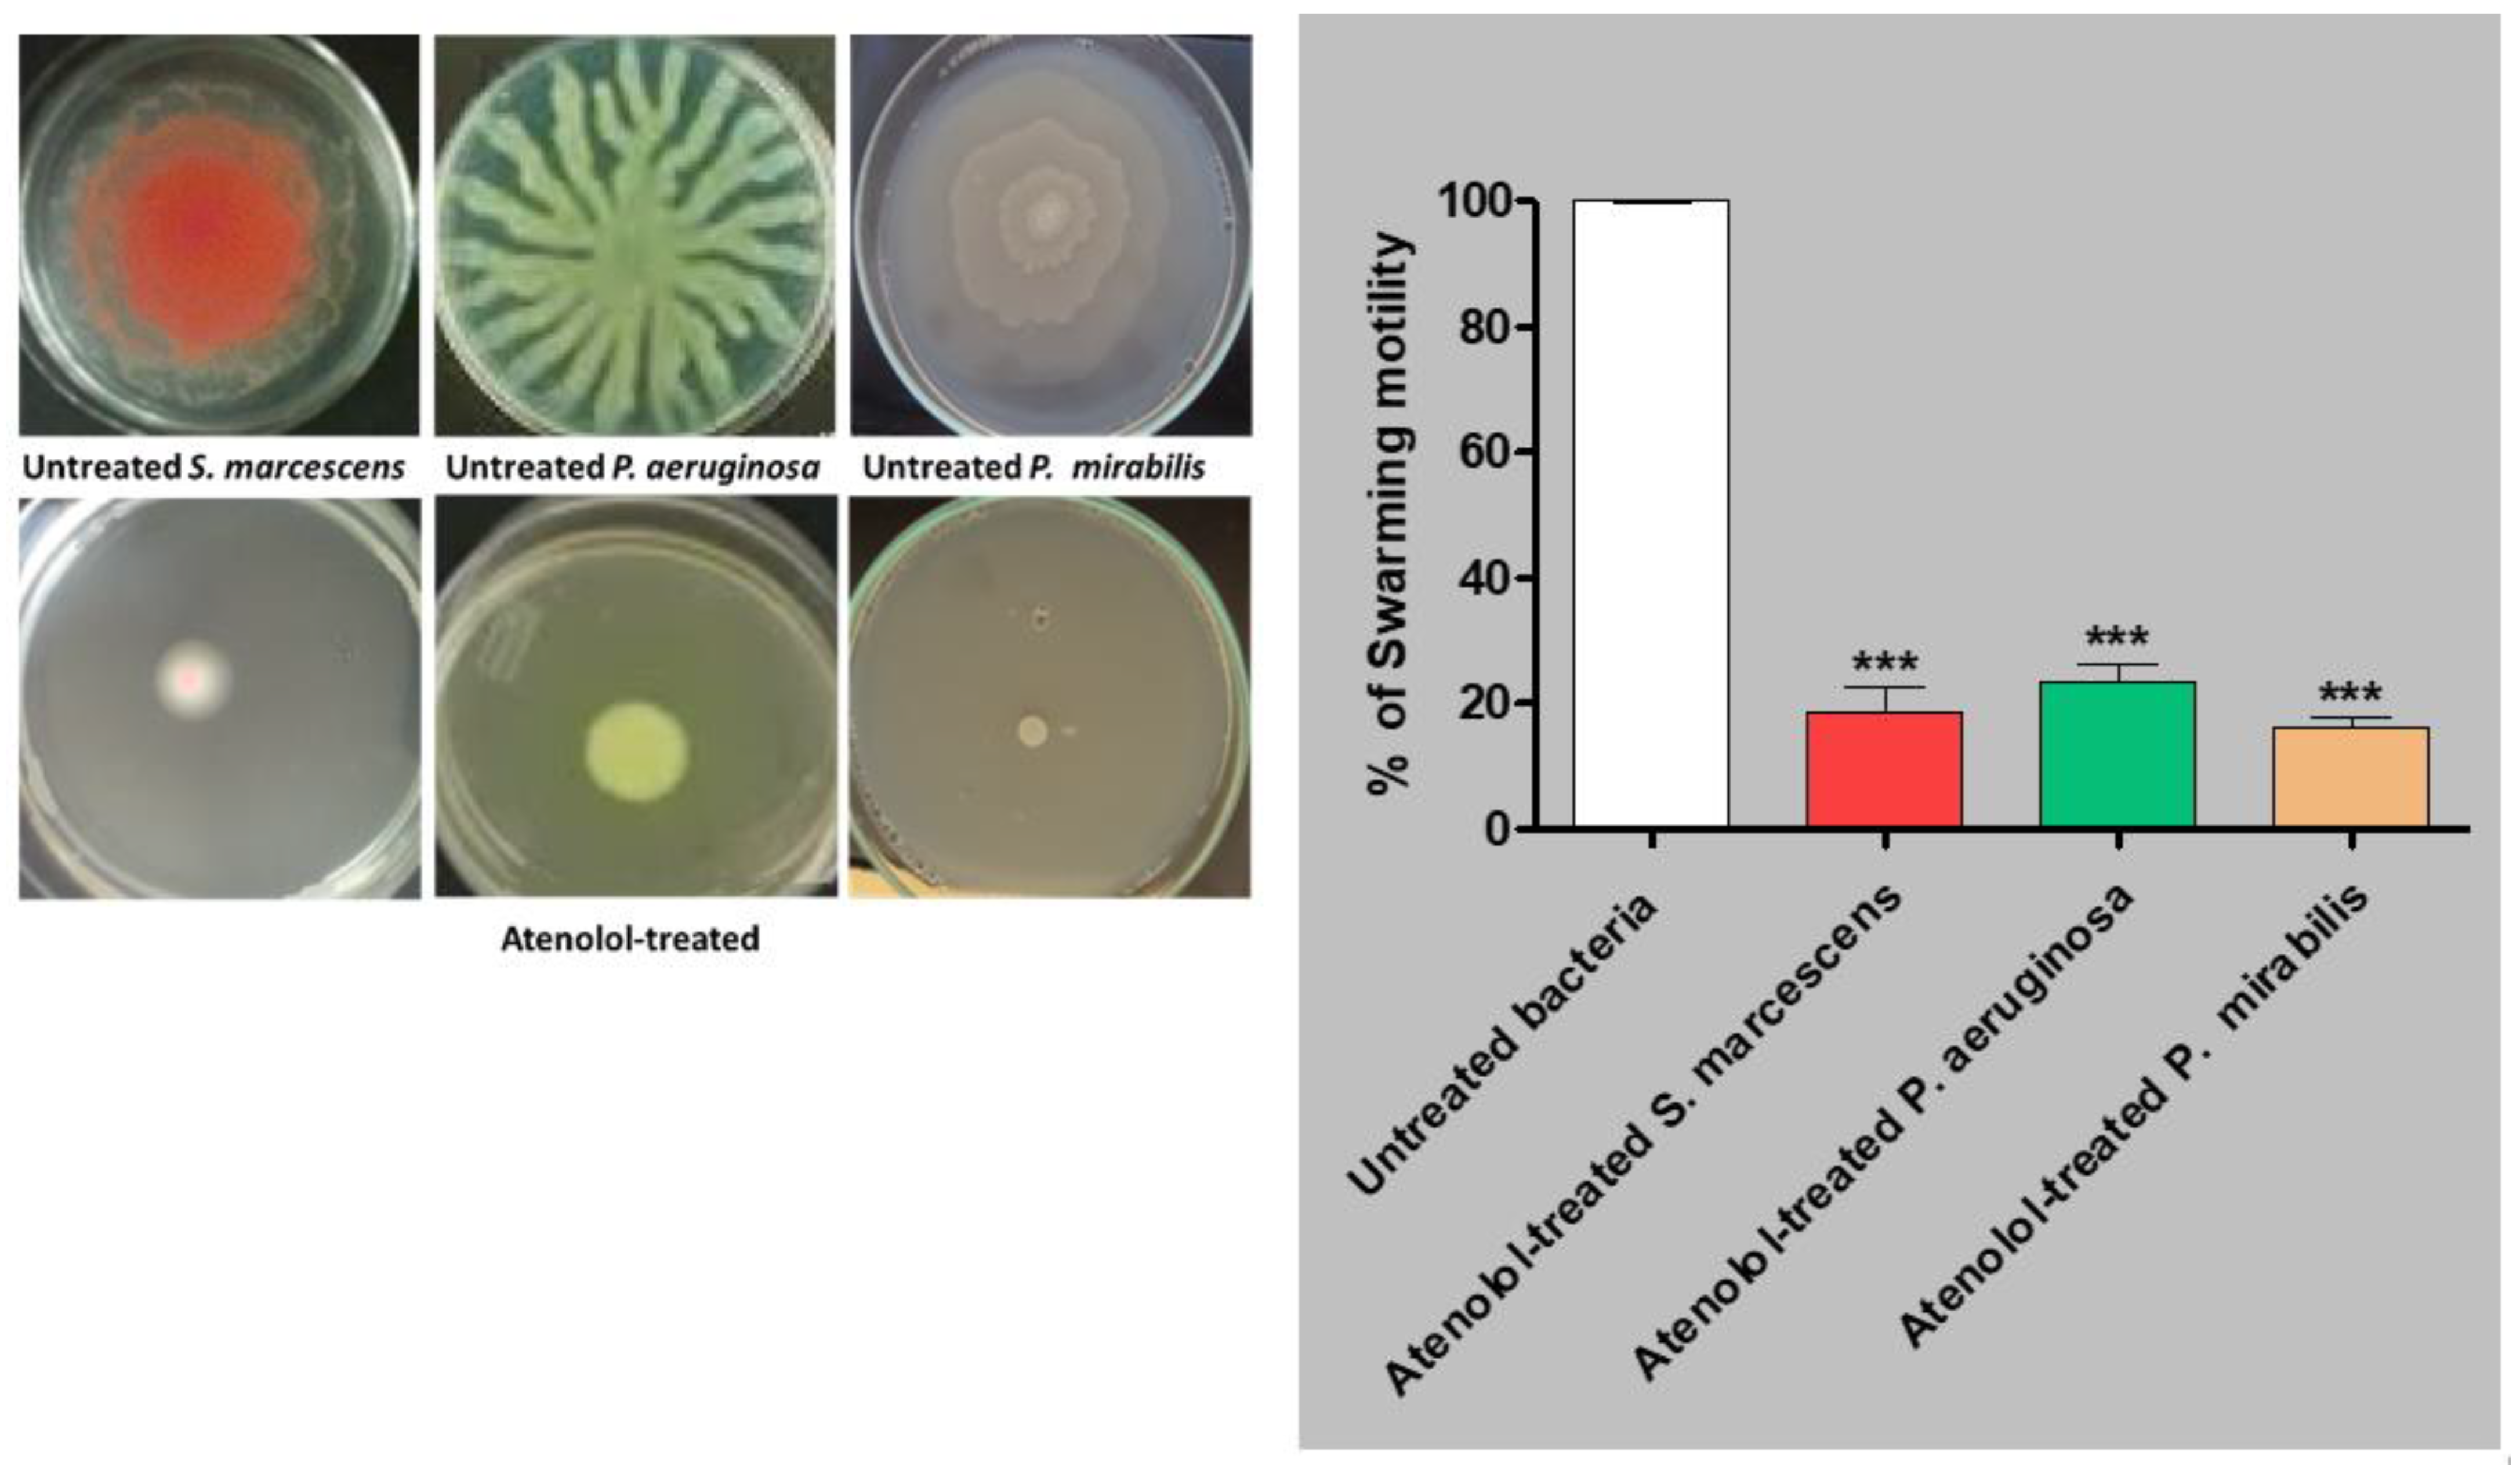
Ijms 23 13088 g010

Characterization of the Anti-Biofilm and Anti-Quorum Sensing Activities of the β-Adrenoreceptor Antagonist Atenolol against Gram-Negative Bacterial Pathogens
Abstract
1. Introduction
2. Results
2.1. In Silico Molecular Study
2.1.1. Screening of Atenolol Binding on Different QS Biotargets
2.1.2. Docking Simulations on P. aeruginosa QS Control Repressor
2.1.3. Docking Simulations on P. mirabilis Adhesin MrpH
2.1.4. Docking Simulations on S. marcescens SmaR
2.2. Minimum Inhibitory Concentration (MIC) of Atenolol
2.3. Effect of Atenolol on Bacterial Growth
2.4. In Vitro Antivirulence and Anti-QS Activities of Atenolol
2.4.1. Antibiofilm Activity
2.4.2. Diminishing of Bacterial Motility
2.4.3. Decreasing Production of Virulence Enzymes
2.5. Atenolol Downregulation of Virulence and QS Genes
2.6. In Vivo Antivirulence and Anti-QS Activities of Atenolol
3. Discussion
4. Materials and Methods
4.1. In Silico Study
4.1.1. Ligand Preparation
4.1.2. Protein Preparation
4.2. Bacterial Strains, and Chemicals
4.3. Effect on Bacterial Growth
4.4. Adhesion and Biofilm Formation
4.5. Bacterial Motility
4.6. Protease Production
4.7. Hemolysins Production
4.8. RT-PCR
4.9. Mice Survival Assay
4.10. Statistical Analysis
5. Conclusions
Author Contributions
Funding
Institutional Review Board Statement
Informed Consent Statement
Data Availability Statement
Acknowledgments
Conflicts of Interest
References
- Winzer, K.; Williams, P. Quorum sensing and the regulation of virulence gene expression in pathogenic bacteria. Int. J. Med. Microbiol. 2001, 291, 131–143. [Google Scholar] [CrossRef] [PubMed]
- Abisado, R.G.; Benomar, S.; Klaus, J.R.; Dandekar, A.A.; Chandler, J.R. Bacterial Quorum Sensing and Microbial Community Interactions. mBio 2018, 9. [Google Scholar] [CrossRef] [PubMed]
- Chen, G.; Swem, L.R.; Swem, D.L.; Stauff, D.L.; O’Loughlin, C.T.; Jeffrey, P.D.; Bassler, B.L.; Hughson, F.M. A strategy for antagonizing quorum sensing. Mol. Cell 2011, 42, 199–209. [Google Scholar] [CrossRef]
- Dong, Y.H.; Wang, L.H.; Xu, J.L.; Zhang, H.B.; Zhang, X.F.; Zhang, L.H. Quenching quorum-sensing-dependent bacterial infection by an N-acyl homoserine lactonase. Nature 2001, 411, 813–817. [Google Scholar] [CrossRef] [PubMed]
- Rutherford, S.T.; Bassler, B.L. Bacterial quorum sensing: Its role in virulence and possibilities for its control. Cold Spring Harb. Perspect. Med. 2012, 2, e02331-17. [Google Scholar] [CrossRef] [PubMed]
- Bottomley, M.J.; Muraglia, E.; Bazzo, R.; Carfi, A. Molecular insights into quorum sensing in the human pathogen Pseudomonas aeruginosa from the structure of the virulence regulator LasR bound to its autoinducer. J. Biol. Chem. 2007, 282, 13592–13600. [Google Scholar] [CrossRef] [PubMed]
- Schneider, R.; Lockatell, C.V.; Johnson, D.; Belas, R. Detection and mutation of a luxS-encoded autoinducer in Proteus mirabilis. Microbiology 2002, 148, 773–782. [Google Scholar] [CrossRef] [PubMed]
- LaSarre, B.; Federle, M.J. Exploiting quorum sensing to confuse bacterial pathogens. Microbiol. Mol. Biol. Rev. 2013, 77, 73–111. [Google Scholar] [CrossRef]
- Lintz, M.J.; Oinuma, K.; Wysoczynski, C.L.; Greenberg, E.P.; Churchill, M.E. Crystal structure of QscR, a Pseudomonas aeruginosa quorum sensing signal receptor. Proc. Natl. Acad. Sci. USA 2011, 108, 15763–15768. [Google Scholar] [CrossRef] [PubMed]
- Pawar, S.; Ashraf, M.I.; Mujawar, S.; Mishra, R.; Lahiri, C. In silico Identification of the Indispensable Quorum Sensing Proteins of Multidrug Resistant Proteus mirabilis. Front. Cell. Infect. Microbiol. 2018, 8, 269. [Google Scholar] [CrossRef] [PubMed]
- Pena, R.T.; Blasco, L.; Ambroa, A.; Gonzalez-Pedrajo, B.; Fernandez-Garcia, L.; Lopez, M.; Bleriot, I.; Bou, G.; Garcia-Contreras, R.; Wood, T.K.; et al. Relationship Between Quorum Sensing and Secretion Systems. Front. Microbiol. 2019, 10, 1100. [Google Scholar] [CrossRef] [PubMed]
- Alandiyjany, M.N.; Abdelaziz, A.S.; Abdelfattah-Hassan, A.; Hegazy, W.A.H.; Hassan, A.A.; Elazab, S.T.; Mohamed, E.A.A.; El-Shetry, E.S.; Saleh, A.A.; ElSawy, N.A.; et al. Novel In Vivo Assessment of Antimicrobial Efficacy of Ciprofloxacin Loaded Mesoporous Silica Nanoparticles against Salmonella typhimurium Infection. Pharmaceuticals 2022, 15, 357. [Google Scholar] [CrossRef] [PubMed]
- Askoura, M.; Almalki, A.J.; Lila, A.S.A.; Almansour, K.; Alshammari, F.; Khafagy, E.-S.; Ibrahim, T.S.; Hegazy, W.A.H. Alteration of Salmonella enterica Virulence and Host Pathogenesis through Targeting sdiA by Using the CRISPR-Cas9 System. Microorganisms 2021, 9, 2564. [Google Scholar] [CrossRef] [PubMed]
- Li, G.; Yan, C.; Xu, Y.; Feng, Y.; Wu, Q.; Lv, X.; Yang, B.; Wang, X.; Xia, X. Punicalagin inhibits Salmonella virulence factors and has anti-quorum-sensing potential. Appl. Environ. Microbiol. 2014, 80, 6204–6211. [Google Scholar] [CrossRef] [PubMed]
- Mattmann, M.E.; Blackwell, H.E. Small molecules that modulate quorum sensing and control virulence in Pseudomonas aeruginosa. J. Org. Chem. 2010, 75, 6737–6746. [Google Scholar] [CrossRef] [PubMed]
- Rasmussen, T.B.; Givskov, M. Quorum-sensing inhibitors as anti-pathogenic drugs. Int. J. Med. Microbiol. 2006, 296, 149–161. [Google Scholar] [CrossRef] [PubMed]
- Choo, J.H.; Rukayadi, Y.; Hwang, J.K. Inhibition of bacterial quorum sensing by vanilla extract. Lett. Appl. Microbiol. 2006, 42, 637–641. [Google Scholar] [CrossRef]
- Brackman, G.; Cos, P.; Maes, L.; Nelis, H.J.; Coenye, T. Quorum sensing inhibitors increase the susceptibility of bacterial biofilms to antibiotics in vitro and in vivo. Antimicrob. Agents Chemother. 2011, 55, 2655–2661. [Google Scholar] [CrossRef]
- Hegazy, W.A.H.; Rajab, A.A.H.; Abu Lila, A.S.; Abbas, H.A. Anti-diabetics and antimicrobials: Harmony of mutual interplay. World J. Diabetes 2021, 12, 1832–1855. [Google Scholar] [CrossRef]
- Hoiby, N.; Bjarnsholt, T.; Givskov, M.; Molin, S.; Ciofu, O. Antibiotic resistance of bacterial biofilms. Int. J. Antimicrob. Agents 2010, 35, 322–332. [Google Scholar] [CrossRef]
- Rasko, D.A.; Moreira, C.G.; de Li, R.; Reading, N.C.; Ritchie, J.M.; Waldor, M.K.; Williams, N.; Taussig, R.; Wei, S.; Roth, M.; et al. Targeting QseC signaling and virulence for antibiotic development. Science 2008, 321, 1078–1080. [Google Scholar] [CrossRef] [PubMed]
- Rasko, D.A.; Sperandio, V. Anti-virulence strategies to combat bacteria-mediated disease. Nat. Rev. Drug. Discov. 2010, 9, 117–128. [Google Scholar] [CrossRef] [PubMed]
- Lister, P.D.; Wolter, D.J.; Hanson, N.D. Antibacterial-resistant Pseudomonas aeruginosa: Clinical impact and complex regulation of chromosomally encoded resistance mechanisms. Clin. Microbiol. Rev. 2009, 22, 582–610. [Google Scholar] [CrossRef] [PubMed]
- Moradali, M.F.; Ghods, S.; Rehm, B.H. Pseudomonas aeruginosa Lifestyle: A Paradigm for Adaptation, Survival, and Persistence. Front. Cell. Infect. Microbiol. 2017, 7, 39. [Google Scholar] [CrossRef]
- Blair, J.M.; Webber, M.A.; Baylay, A.J.; Ogbolu, D.O.; Piddock, L.J. Molecular mechanisms of antibiotic resistance. Nat. Rev. Microbiol. 2015, 13, 42–51. [Google Scholar] [CrossRef]
- Garcia-Contreras, R.; Nunez-Lopez, L.; Jasso-Chavez, R.; Kwan, B.W.; Belmont, J.A.; Rangel-Vega, A.; Maeda, T.; Wood, T.K. Quorum sensing enhancement of the stress response promotes resistance to quorum quenching and prevents social cheating. ISME J. 2015, 9, 115–125. [Google Scholar] [CrossRef]
- Huang, C.T.; Shih, P.C. Effects of quorum sensing signal molecules on the hydrogen peroxide resistance against planktonic Pseudomonas aeruginosa. J. Microbiol. Immunol. Infect. 2000, 33, 154–158. [Google Scholar]
- Abd El-Hamid, M.I.; Sewid, A.H.; Samir, M.; Hegazy, W.A.H.; Bahnass, M.M.; Mosbah, R.A.; Ghaith, D.M.; Khalifa, E.; Ramadan, H.; Alshareef, W.A.; et al. Clonal Diversity and Epidemiological Characteristics of ST239-MRSA Strains. Front. Cell. Infect. Microbiol. 2022, 12, 241. [Google Scholar] [CrossRef]
- Srinivasan, R.; Mohankumar, R.; Kannappan, A.; Karthick Raja, V.; Archunan, G.; Karutha Pandian, S.; Ruckmani, K.; Veera Ravi, A. Exploring the Anti-quorum Sensing and Antibiofilm Efficacy of Phytol against Serratia marcescens Associated Acute Pyelonephritis Infection in Wistar Rats. Front. Cell. Infect. Microbiol. 2017, 7, 498. [Google Scholar] [CrossRef]
- Muhlen, S.; Dersch, P. Anti-virulence Strategies to Target Bacterial Infections. Curr. Top. Microbiol. Immunol. 2016, 398, 147–183. [Google Scholar] [CrossRef]
- Hentzer, M.; Wu, H.; Andersen, J.B.; Riedel, K.; Rasmussen, T.B.; Bagge, N.; Kumar, N.; Schembri, M.A.; Song, Z.; Kristoffersen, P.; et al. Attenuation of Pseudomonas aeruginosa virulence by quorum sensing inhibitors. EMBO J. 2003, 22, 3803–3815. [Google Scholar] [CrossRef] [PubMed]
- Jiang, Q.; Chen, J.; Yang, C.; Yin, Y.; Yao, K. Quorum Sensing: A Prospective Therapeutic Target for Bacterial Diseases. BioMed Res. Int. 2019, 2019, 2015978. [Google Scholar] [CrossRef] [PubMed]
- Jiang, T.; Li, M. Quorum sensing inhibitors: A patent review. Expert Opin. Ther. Pat. 2013, 23, 867–894. [Google Scholar] [CrossRef] [PubMed]
- Papenfort, K.; Bassler, B.L. Quorum sensing signal-response systems in Gram-negative bacteria. Nat. Rev. Microbiol. 2016, 14, 576–588. [Google Scholar] [CrossRef]
- Livermore, D.M.; Blaser, M.; Carrs, O.; Cassell, G.; Fishman, N.; Guidos, R.; Levy, S.; Powers, J.; Norrby, R.; Tillotson, G.; et al. Discovery research: The scientific challenge of finding new antibiotics. J. Antimicrob. Chemother. 2011, 66, 1941–1944. [Google Scholar] [CrossRef]
- Almalki, A.J.; Ibrahim, T.S.; Taher, E.S.; Mohamed, M.F.A.; Youns, M.; Hegazy, W.A.H.; Al-Mahmoudy, A.M.M. Synthesis, Antimicrobial, Anti-Virulence and Anticancer Evaluation of New 5(4H)-Oxazolone-Based Sulfonamides. Molecules 2022, 27, 671. [Google Scholar] [CrossRef]
- Agha, K.A.; Abo-Dya, N.E.; Ibrahim, T.S.; Abdel-Aal, E.H.; Hegazy, W.A. Benzotriazole-Mediated Synthesis and Antibacterial Activity of Novel N-Acylcephalexins. Sci. Pharm. 2016, 84, 484–496. [Google Scholar] [CrossRef]
- Ma, D.L.; Chan, D.S.; Leung, C.H. Drug repositioning by structure-based virtual screening. Chem. Soc. Rev. 2013, 42, 2130–2141. [Google Scholar] [CrossRef]
- Khayat, M.T.; Ibrahim, T.S.; Khayyat, A.N.; Alharbi, M.; Shaldam, M.A.; Mohammad, K.A.; Khafagy, E.-S.; El-damasy, D.A.; Hegazy, W.A.H.; Abbas, H.A. Sodium Citrate Alleviates Virulence in Pseudomonas aeruginosa. Microorganisms 2022, 10, 1046. [Google Scholar] [CrossRef]
- Aldawsari, M.F.; Khafagy, E.S.; Saqr, A.A.; Alalaiwe, A.; Abbas, H.A.; Shaldam, M.A.; Hegazy, W.A.H.; Goda, R.M. Tackling Virulence of Pseudomonas aeruginosa by the Natural Furanone Sotolon. Antibiotics 2021, 10, 871. [Google Scholar] [CrossRef]
- Almalki, A.J.; Ibrahim, T.S.; Elhady, S.S.; Darwish, K.M.; Hegazy, W.A.H. Repurposing α-Adrenoreceptor Blockers as Promising Anti-Virulence Agents in Gram-Negative Bacteria. Antibiotics 2022, 11, 178. [Google Scholar] [CrossRef] [PubMed]
- Almalki, A.J.; Ibrahim, T.S.; Elhady, S.S.; Hegazy, W.A.H.; Darwish, K.M. Computational and Biological Evaluation of β-Adrenoreceptor Blockers as Promising Bacterial Anti-Virulence Agents. Pharmaceuticals 2022, 15, 110. [Google Scholar] [CrossRef] [PubMed]
- Hegazy, W.A.H.; Salem, I.M.; Alotaibi, H.F.; Khafagy, E.-S.; Ibrahim, D. Terazosin Interferes with Quorum Sensing and Type Three Secretion System and Diminishes the Bacterial Espionage to Mitigate the Salmonella Typhimurium Pathogenesis. Antibiotics 2022, 11, 465. [Google Scholar] [CrossRef] [PubMed]
- Saqr, A.A.; Aldawsari, M.F.; Khafagy, E.-S.; Shaldam, M.A.; Hegazy, W.A.H.; Abbas, H.A. A Novel Use of Allopurinol as A Quorum-Sensing Inhibitor in Pseudomonas aeruginosa. Antibiotics 2021, 10, 1385. [Google Scholar] [CrossRef] [PubMed]
- Pushpakom, S.; Iorio, F.; Eyers, P.A.; Escott, K.J.; Hopper, S.; Wells, A.; Doig, A.; Guilliams, T.; Latimer, J.; McNamee, C.; et al. Drug repurposing: Progress, challenges and recommendations. Nat. Rev. Drug. Discov. 2019, 18, 41–58. [Google Scholar] [CrossRef] [PubMed]
- Mohr, K.I. History of Antibiotics Research. Curr. Top. Microbiol. Immunol. 2016, 398, 237–272. [Google Scholar] [CrossRef] [PubMed]
- Aykac, A.; Sehirli, A.O.; Goren, M.Z. Evaluation of the Effect of Prazosin Treatment on alpha-2c Adrenoceptor and Apoptosis Protein Levels in the Predator Scent-Induced Rat Model of Post-Traumatic Stress Disorder. J. Mol. Neurosci. 2020, 70, 1120–1129. [Google Scholar] [CrossRef] [PubMed]
- Jiang, W.; Ubhayasekera, W.; Breed, M.C.; Norsworthy, A.N.; Serr, N.; Mobley, H.L.T.; Pearson, M.M.; Knight, S.D. MrpH, a new class of metal-binding adhesin, requires zinc to mediate biofilm formation. PLoS Pathog. 2020, 16, e1008707. [Google Scholar] [CrossRef]
- Khayyat, A.N.; Abbas, H.A.; Mohamed, M.F.A.; Asfour, H.Z.; Khayat, M.T.; Ibrahim, T.S.; Youns, M.; Khafagy, E.-S.; Abu Lila, A.S.; Safo, M.K.; et al. Not Only Antimicrobial: Metronidazole Mitigates the Virulence of Proteus mirabilis Isolated from Macerated Diabetic Foot Ulcer. Appl. Sci. 2021, 11, 6847. [Google Scholar] [CrossRef]
- Waterhouse, A.; Bertoni, M.; Bienert, S.; Studer, G.; Tauriello, G.; Gumienny, R.; Heer, F.T.; de Beer, T.A.P.; Rempfer, C.; Bordoli, L.; et al. SWISS-MODEL: Homology modelling of protein structures and complexes. Nucleic Acids Res. 2018, 46, W296–W303. [Google Scholar] [CrossRef]
- Bienert, S.; Waterhouse, A.; de Beer, T.A.; Tauriello, G.; Studer, G.; Bordoli, L.; Schwede, T. The SWISS-MODEL Repository-new features and functionality. Nucleic Acids Res. 2017, 45, D313–D319. [Google Scholar] [CrossRef] [PubMed]
- Studer, G.; Rempfer, C.; Waterhouse, A.M.; Gumienny, R.; Haas, J.; Schwede, T. QMEANDisCo-distance constraints applied on model quality estimation. Bioinformatics 2020, 36, 2647. [Google Scholar] [CrossRef] [PubMed]
- Studer, G.; Tauriello, G.; Bienert, S.; Biasini, M.; Johner, N.; Schwede, T. ProMod3-A versatile homology modelling toolbox. PLoS Comput. Biol. 2021, 17, e1008667. [Google Scholar] [CrossRef]
- Bertoni, M.; Kiefer, F.; Biasini, M.; Bordoli, L.; Schwede, T. Modeling protein quaternary structure of homo- and hetero-oligomers beyond binary interactions by homology. Sci. Rep. 2017, 7, 10480. [Google Scholar] [CrossRef]
- Issac Abraham, S.V.; Palani, A.; Ramaswamy, B.R.; Shunmugiah, K.P.; Arumugam, V.R. Antiquorum sensing and antibiofilm potential of Capparis spinosa. Arch. Med. Res. 2011, 42, 658–668. [Google Scholar] [CrossRef]
- Gaynes, R.; Edwards, J.R.; National Nosocomial Infections Surveillance, S. Overview of nosocomial infections caused by gram-negative bacilli. Clin. Infect. Dis. Off. Publ. Infect. Dis. Soc. Am. 2005, 41, 848–854. [Google Scholar] [CrossRef]
- Pang, Z.; Raudonis, R.; Glick, B.R.; Lin, T.J.; Cheng, Z. Antibiotic resistance in Pseudomonas aeruginosa: Mechanisms and alternative therapeutic strategies. Biotechnol. Adv. 2019, 37, 177–192. [Google Scholar] [CrossRef]
- Skindersoe, M.E.; Alhede, M.; Phipps, R.; Yang, L.; Jensen, P.O.; Rasmussen, T.B.; Bjarnsholt, T.; Tolker-Nielsen, T.; Hoiby, N.; Givskov, M. Effects of antibiotics on quorum sensing in Pseudomonas aeruginosa. Antimicrob. Agents Chemother. 2008, 52, 3648–3663. [Google Scholar] [CrossRef]
- Kamaruzzaman, N.F.; Kendall, S.; Good, L. Targeting the hard to reach: Challenges and novel strategies in the treatment of intracellular bacterial infections. Br. J. Pharmacol. 2017, 174, 2225–2236. [Google Scholar] [CrossRef]
- Cegelski, L.; Marshall, G.R.; Eldridge, G.R.; Hultgren, S.J. The biology and future prospects of antivirulence therapies. Nat. Rev. Microbiol. 2008, 6, 17–27. [Google Scholar] [CrossRef]
- Hema, M.; Vasudevan, S.; Balamurugan, P.; Adline Princy, S. Modulating the Global Response Regulator, LuxO of V. cholerae Quorum Sensing System Using a Pyrazine Dicarboxylic Acid Derivative (PDCA(py)): An Antivirulence Approach. Front. Cell. Infect. Microbiol. 2017, 7, 441. [Google Scholar] [CrossRef] [PubMed]
- Burt, S.A.; Ojo-Fakunle, V.T.; Woertman, J.; Veldhuizen, E.J. The natural antimicrobial carvacrol inhibits quorum sensing in Chromobacterium violaceum and reduces bacterial biofilm formation at sub-lethal concentrations. PLoS ONE 2014, 9, e93414. [Google Scholar] [CrossRef] [PubMed]
- Diggle, S.P.; Matthijs, S.; Wright, V.J.; Fletcher, M.P.; Chhabra, S.R.; Lamont, I.L.; Kong, X.; Hider, R.C.; Cornelis, P.; Camara, M.; et al. The Pseudomonas aeruginosa 4-quinolone signal molecules HHQ and PQS play multifunctional roles in quorum sensing and iron entrapment. Chem. Biol. 2007, 14, 87–96. [Google Scholar] [CrossRef]
- Hegazy, W.A.H.; Khayat, M.T.; Ibrahim, T.S.; Youns, M.; Mosbah, R.; Soliman, W.E. Repurposing of antidiabetics as Serratia marcescens virulence inhibitors. Braz. J. Microbiol. 2021, 52, 627–638. [Google Scholar] [CrossRef]
- Hegazy, W.A.H.; Khayat, M.T.; Ibrahim, T.S.; Nassar, M.S.; Bakhrebah, M.A.; Abdulaal, W.H.; Alhakamy, N.A.; Bendary, M.M. Repurposing Anti-diabetic Drugs to Cripple Quorum Sensing in Pseudomonas aeruginosa. Microorganisms 2020, 8, 1285. [Google Scholar] [CrossRef] [PubMed]
- Khayat, M.T.; Abbas, H.A.; Ibrahim, T.S.; Khayyat, A.N.; Alharbi, M.; Darwish, K.M.; Elhady, S.S.; Khafagy, E.-S.; Safo, M.K.; Hegazy, W.A.H. Anti-Quorum Sensing Activities of Gliptins against Pseudomonas aeruginosa and Staphylococcus aureus. Biomedicines 2022, 10, 1169. [Google Scholar] [CrossRef]
- Thabit, A.K.; Eljaaly, K.; Zawawi, A.; Ibrahim, T.S.; Eissa, A.G.; Elbaramawi, S.S.; Hegazy, W.A.H.; Elfaky, M.A. Muting Bacterial Communication: Evaluation of Prazosin Anti-Quorum Sensing Activities against Gram-Negative Bacteria Pseudomonas aeruginosa, Proteus mirabilis, and Serratia marcescens. Biology 2022, 11, 1349. [Google Scholar] [CrossRef] [PubMed]
- Rather, P.N. Swarmer cell differentiation in Proteus mirabilis. Environ. Microbiol. 2005, 7, 1065–1073. [Google Scholar] [CrossRef]
- Rozalski, A.; Sidorczyk, Z.; Kotelko, K. Potential virulence factors of Proteus bacilli. Microbiol. Mol. Biol. Rev. 1997, 61, 65–89. [Google Scholar] [CrossRef]
- Girlich, D.; Bonnin, R.A.; Dortet, L.; Naas, T. Genetics of Acquired Antibiotic Resistance Genes in Proteus spp. Front. Microbiol. 2020, 11, 256. [Google Scholar] [CrossRef]
- Liaw, S.J.; Lai, H.C.; Ho, S.W.; Luh, K.T.; Wang, W.B. Role of RsmA in the regulation of swarming motility and virulence factor expression in Proteus mirabilis. J. Med. Microbiol. 2003, 52, 19–28. [Google Scholar] [CrossRef] [PubMed]
- Schaffer, J.N.; Norsworthy, A.N.; Sun, T.T.; Pearson, M.M. Proteus mirabilis fimbriae- and urease-dependent clusters assemble in an extracellular niche to initiate bladder stone formation. Proc. Natl. Acad. Sci. USA 2016, 113, 4494–4499. [Google Scholar] [CrossRef] [PubMed]
- Armbruster, C.E.; Mobley, H.L. Merging mythology and morphology: The multifaceted lifestyle of Proteus mirabilis. Nat. Rev. Microbiol. 2012, 10, 743–754. [Google Scholar] [CrossRef] [PubMed]
- Khayyat, A.N.; Abbas, H.A.; Khayat, M.T.; Shaldam, M.A.; Askoura, M.; Asfour, H.Z.; Khafagy, E.-S.; Abu Lila, A.S.; Allam, A.N.; Hegazy, W.A.H. Secnidazole Is a Promising Imidazole Mitigator of Serratia marcescens Virulence. Microorganisms 2021, 9, 2333. [Google Scholar] [CrossRef]
- Stock, I.; Burak, S.; Sherwood, K.J.; Gruger, T.; Wiedemann, B. Natural antimicrobial susceptibilities of strains of ’unusual’ Serratia species: S. ficaria, S. fonticola, S. odorifera, S. plymuthica and S. rubidaea. J. Antimicrob. Chemother. 2003, 51, 865–885. [Google Scholar] [CrossRef]
- Matsuyama, T.; Kaneda, K.; Nakagawa, Y.; Isa, K.; Hara-Hotta, H.; Yano, I. A novel extracellular cyclic lipopeptide which promotes flagellum-dependent and -independent spreading growth of Serratia marcescens. J. Bacteriol. 1992, 174, 1769–1776. [Google Scholar] [CrossRef]
- Salini, R.; Pandian, S.K. Interference of quorum sensing in urinary pathogen Serratia marcescens by Anethum graveolens. Pathog. Dis. 2015, 73, ftv038. [Google Scholar] [CrossRef]
- Slater, H.; Crow, M.; Everson, L.; Salmond, G.P. Phosphate availability regulates biosynthesis of two antibiotics, prodigiosin and carbapenem, in Serratia via both quorum-sensing-dependent and -independent pathways. Mol. Microbiol. 2003, 47, 303–320. [Google Scholar] [CrossRef]
- Oliver, A.; Mulet, X.; Lopez-Causape, C.; Juan, C. The increasing threat of Pseudomonas aeruginosa high-risk clones. Drug Resist. Updates Rev. Comment. Antimicrob. Anticancer. Chemother. 2015, 21–22, 41–59. [Google Scholar] [CrossRef]
- Horcajada, J.P.; Montero, M.; Oliver, A.; Sorli, L.; Luque, S.; Gomez-Zorrilla, S.; Benito, N.; Grau, S. Epidemiology and Treatment of Multidrug-Resistant and Extensively Drug-Resistant Pseudomonas aeruginosa Infections. Clin. Microbiol. Rev. 2019, 32. [Google Scholar] [CrossRef]
- Venturi, V. Regulation of quorum sensing in Pseudomonas. FEMS Microbiol. Rev. 2006, 30, 274–291. [Google Scholar] [CrossRef] [PubMed]
- Moreira, C.G.; Sperandio, V. Interplay between the QseC and QseE bacterial adrenergic sensor kinases in Salmonella enterica serovar Typhimurium pathogenesis. Infect. Immun. 2012, 80, 4344–4353. [Google Scholar] [CrossRef]
- Withers, H.; Swift, S.; Williams, P. Quorum sensing as an integral component of gene regulatory networks in Gram-negative bacteria. Curr. Opin. Microbiol. 2001, 4, 186–193. [Google Scholar] [CrossRef]
- Yu, Z.; Hu, Z.; Xu, Q.; Zhang, M.; Yuan, N.; Liu, J.; Meng, Q.; Yin, J. The LuxI/LuxR-Type Quorum Sensing System Regulates Degradation of Polycyclic Aromatic Hydrocarbons via Two Mechanisms. Int. J. Mol. Sci. 2020, 21, 5548. [Google Scholar] [CrossRef] [PubMed]
- Moreira, C.G.; Russell, R.; Mishra, A.A.; Narayanan, S.; Ritchie, J.M.; Waldor, M.K.; Curtis, M.M.; Winter, S.E.; Weinshenker, D.; Sperandio, V. Bacterial Adrenergic Sensors Regulate Virulence of Enteric Pathogens in the Gut. mBio 2016, 7. [Google Scholar] [CrossRef]
- Flierl, M.A.; Rittirsch, D.; Nadeau, B.A.; Sarma, J.V.; Day, D.E.; Lentsch, A.B.; Huber-Lang, M.S.; Ward, P.A. Upregulation of phagocyte-derived catecholamines augments the acute inflammatory response. PLoS ONE 2009, 4, e4414. [Google Scholar] [CrossRef]
- Methner, U.; Rabsch, W.; Reissbrodt, R.; Williams, P.H. Effect of norepinephrine on colonisation and systemic spread of Salmonella enterica in infected animals: Role of catecholate siderophore precursors and degradation products. Int. J. Med. Microbiol. 2008, 298, 429–439. [Google Scholar] [CrossRef]
- Sandrini, S.M.; Shergill, R.; Woodward, J.; Muralikuttan, R.; Haigh, R.D.; Lyte, M.; Freestone, P.P. Elucidation of the mechanism by which catecholamine stress hormones liberate iron from the innate immune defense proteins transferrin and lactoferrin. J. Bacteriol. 2010, 192, 587–594. [Google Scholar] [CrossRef] [PubMed]
- Stevens, A.M.; Dolan, K.M.; Greenberg, E.P. Synergistic binding of the Vibrio fischeri LuxR transcriptional activator domain and RNA polymerase to the lux promoter region. Proc. Natl. Acad. Sci. USA 1994, 91, 12619–12623. [Google Scholar] [CrossRef]
- Bode, N.J.; Debnath, I.; Kuan, L.; Schulfer, A.; Ty, M.; Pearson, M.M. Transcriptional analysis of the MrpJ network: Modulation of diverse virulence-associated genes and direct regulation of mrp fimbrial and flhDC flagellar operons in Proteus mirabilis. Infect. Immun. 2015, 83, 2542–2556. [Google Scholar] [CrossRef]
- Garcia-Contreras, R. Is Quorum Sensing Interference a Viable Alternative to Treat Pseudomonas aeruginosa Infections? Front. Microbiol. 2016, 7, 1454. [Google Scholar] [CrossRef] [PubMed]
- Ang, S.; Horng, Y.T.; Shu, J.C.; Soo, P.C.; Liu, J.H.; Yi, W.C.; Lai, H.C.; Luh, K.T.; Ho, S.W.; Swift, S. The role of RsmA in the regulation of swarming motility in Serratia marcescens. J. Biomed. Sci. 2001, 8, 160–169. [Google Scholar] [CrossRef] [PubMed]
- Lin, C.S.; Tsai, Y.H.; Chang, C.J.; Tseng, S.F.; Wu, T.R.; Lu, C.C.; Wu, T.S.; Lu, J.J.; Horng, J.T.; Martel, J.; et al. An iron detection system determines bacterial swarming initiation and biofilm formation. Sci. Rep. 2016, 6, 36747. [Google Scholar] [CrossRef] [PubMed]
- Ramanathan, S.; Ravindran, D.; Arunachalam, K.; Arumugam, V.R. Inhibition of quorum sensing-dependent biofilm and virulence genes expression in environmental pathogen Serratia marcescens by petroselinic acid. Antonie Van Leeuwenhoek 2018, 111, 501–515. [Google Scholar] [CrossRef]
- Tian, W.; Chen, C.; Lei, X.; Zhao, J.; Liang, J. CASTp 3.0: Computed atlas of surface topography of proteins. Nucleic Acids Res. 2018, 46, W363–W367. [Google Scholar] [CrossRef]
- Hegazy, W.A.H. Diclofenac inhibits virulence of Proteus mirabilis isolated from diabetic foot ulcer. Afr. J. Microbiol. Res. 2016, 10, 733–743. [Google Scholar]
- Abbas, H.A.; Hegazy, W.A.H. Targeting the virulence factors of Serratia marcescens by ambroxol. Roum. Arch. Microbiol. Immunol. 2017, 76, 27–32. [Google Scholar]
- Abbas, H.A.; Hegazy, W.A.H. Repurposing anti-diabetic drug “Sitagliptin” as a novel virulence attenuating agent in Serratia marcescens. PLoS ONE 2020, 15, e0231625. [Google Scholar] [CrossRef]
- Mavrodi, D.V.; Bonsall, R.F.; Delaney, S.M.; Soule, M.J.; Phillips, G.; Thomashow, L.S. Functional analysis of genes for biosynthesis of pyocyanin and phenazine-1-carboxamide from Pseudomonas aeruginosa PAO1. J. Bacteriol. 2001, 183, 6454–6465. [Google Scholar] [CrossRef]
- Nalca, Y.; Jansch, L.; Bredenbruch, F.; Geffers, R.; Buer, J.; Haussler, S. Quorum-sensing antagonistic activities of azithromycin in Pseudomonas aeruginosa PAO1: A global approach. Antimicrob. Agents Chemother. 2006, 50, 1680–1688. [Google Scholar] [CrossRef]
- Hegazy, W.A.H.; Abbas, H.A. Evaluation of the role of SsaV ‘Salmonella pathogenicity island-2 dependent type III secretion system components on the virulence behavior of Salmonella enterica serovar Typhimurium. Afr. J. Biotechnol. 2017, 16, 718–726. [Google Scholar] [CrossRef]
- Youns, M.; Askoura, M.; Abbas, H.A.; Attia, G.H.; Khayyat, A.N.; Goda, R.M.; Almalki, A.J.; Khafagy, E.S.; Hegazy, W.A.H. Celastrol Modulates Multiple Signaling Pathways to Inhibit Proliferation of Pancreatic Cancer via DDIT3 and ATF3 Up-Regulation and RRM2 and MCM4 Down-Regulation. Onco. Targets. Ther. 2021, 14, 3849–3860. [Google Scholar] [CrossRef] [PubMed]
- Parai, D.; Banerjee, M.; Dey, P.; Chakraborty, A.; Islam, E.; Mukherjee, S.K. Effect of reserpine on Pseudomonas aeruginosa quorum sensing mediated virulence factors and biofilm formation. Biofouling 2018, 34, 320–334. [Google Scholar] [CrossRef]
- Gruber, J.D.; Chen, W.; Parnham, S.; Beauchesne, K.; Moeller, P.; Flume, P.A.; Zhang, Y.M. The role of 2,4-dihydroxyquinoline (DHQ) in Pseudomonas aeruginosa pathogenicity. PeerJ 2016, 4, e1495. [Google Scholar] [CrossRef] [PubMed]
- Kim, H.S.; Lee, S.H.; Byun, Y.; Park, H.D. 6-Gingerol reduces Pseudomonas aeruginosa biofilm formation and virulence via quorum sensing inhibition. Sci. Rep. 2015, 5, 8656. [Google Scholar] [CrossRef] [PubMed]

| Ligand | Rigid Receptor Protocol | Induced-Fit Protocol | H-Bond Interactions | Hydrophobic Interactions | Ionic-Bond Interactions | ||
|---|---|---|---|---|---|---|---|
| S Score Kcal/mol | RMSD | S Score Kcal/mol | RMSD | ||||
| Atenolol | −7.4614 | 1.4216 | −7.5851 | 1.0032 | Tyr58 and Gly40 | Ser38, Phe54, Tyr52, Tyr58, Tyr66, Val78 and Met127 | Asp75 |
| 3OC12-HSL | −10.4256 | 1.2495 | −10.1774 | 1.1676 | Tyr58, Trp62 and Asp75 | Ser38, Tyr52, Phe54, Tyr58, Tyr66, Val78 and Met127 | - |
| Ligand | Rigid Receptor Protocol | Induced-Fit Protocol | H-Bond Interactions | Hydrophobic Interactions | pi-Interactions | ||
|---|---|---|---|---|---|---|---|
| S Score Kcal/mol | RMSD | S Score Kcal/mol | RMSD | ||||
| Atenolol | −6.3937 | 1.5832 | −7.2011 | 1.1977 | Ala84 and Arg118. In addition to ionic bond with zinc metal | Asn82, Ala84, Phe85, Thr115 Thr116, Arg118 and Ile140 | Asn82 (pi-H) |
| Glutamate | −8.2383 | 0.9710 | −8.4332 | 1.4964 | Asn 82, Thr116, His117 and Arg118. In addition to ionic bond with zinc metal | Asn 82, Thr116, Arg118 and Ile140 | - |
| Ligand | Rigid Receptor Protocol | Induced-Fit Protocol | Interactions | |||||
|---|---|---|---|---|---|---|---|---|
| S Score Kcal/mol | RMSD | S Score Kcal/mol | RMSD | H-Bond | Hydrophobic | Ionic | Pi | |
| Atenolol | −5.9927 | 1.2627 | −5.7653 | 1.0260 | Asp66 | Phe44, Phe54, Tyr57, Asp66, Val68, Trp81 and Ile105 | Asp66 | Phe44, Tyr57 and Trp81 |
| HLC | −6.9484 | 1.3639 | −7.1761 | 1.3923 | Trp53 | Ala32, Phe44, Tyr57, Trp81, Ile105, Val122 and Ser124 | - | - |
| Target Gene | Sequence (5′–3′) | Gene Significance | Reference |
|---|---|---|---|
| lasI | For: CTACAGCCTGCAGAACGACA Rev: ATCTGGGTCTTGGCATTGAG | P. aeruginosa QS autoinducer synthetase | [103] |
| lasR | For: ACGCTCAAGTGGAAAATTGG Rev: GTAGATGGACGGTTCCCAGA | P. aeruginosa QS receptor | [103] |
| rhlI | For: CTCTCTGAATCGCTGGAAGG Rev: GACGTCCTTGAGCAGGTAGG | P. aeruginosa QS autoinducer synthetase | [103] |
| rhlR | For: AGGAATGACGGAGGCTTTTT Rev: CCCGTAGTTCTGCATCTGGT | P. aeruginosa QS receptor | [103] |
| pqsA | For: TTCTGTTCCGCCTCGATTTC Rev: AGTCGTTCAACGCCAGCAC | P. aeruginosa QS autoinducer synthetase | [104] |
| pqsR | For: AACCTGGAAATCGACCTGTG Rev: TGAAATCGTCGAGCAGTACG | P. aeruginosa QS receptor | [103] |
| rpoD | For: GGGCGAAGAAGGAAATGGTC Rev: CAGGTGGCGTAGGTGGAGAAC | Housekeeping for P. aeruginosa genes | [104] |
| fimA | For: ACTACACCCTGCGTTTCGAC Rev: GCGTTAGAGTTTGCCTGACC | S. marcescens fimbria | [77] |
| fimC | For: AAGATCGCACCGTACAAACC Rev: TTTGCACCGCATAGTTCAAG | S. marcescens fimbria | [77] |
| flhc | For: AAGAAGCCAAGGACATTCAG Rev: TTCCCAGGTCATAAACCAGT | S. marcescens flagella | [29] |
| flhD | For: TGTCGGGATGGGGAATATGG Rev: CGATAGCTCTTGCAGTAAATGG | S. marcescens flagella | [29] |
| bsmB | For:CCGCCTGCAAGAAAGAACTT Rev: AGAGATCGACGGTCAGTTCC | S. marcescens type I pilus | [29] |
| rsmA | For: TTGGTGAAACCCTCATGATT Rev: GCTTCGGAATCAGTAAGTCG | S. marcescens motility | [29] |
| rssB | For:TAACGAACTGCTGATGCTGT Rev: GATCTTGCGCCGTAAATTAT | S. marcescens motility | [29] |
| rplU | For: GCTTGGAAAAGCTGGACATC Rev: TACGGTGGTGTTTACGACGA | Housekeeping for S. marcescens genes | [29] |
Publisher’s Note: MDPI stays neutral with regard to jurisdictional claims in published maps and institutional affiliations. |
© 2022 by the authors. Licensee MDPI, Basel, Switzerland. This article is an open access article distributed under the terms and conditions of the Creative Commons Attribution (CC BY) license (https://creativecommons.org/licenses/by/4.0/).
Share and Cite
Cavalu, S.; Elbaramawi, S.S.; Eissa, A.G.; Radwan, M.F.; S. Ibrahim, T.; Khafagy, E.-S.; Lopes, B.S.; Ali, M.A.M.; Hegazy, W.A.H.; Elfaky, M.A. Characterization of the Anti-Biofilm and Anti-Quorum Sensing Activities of the β-Adrenoreceptor Antagonist Atenolol against Gram-Negative Bacterial Pathogens. Int. J. Mol. Sci. 2022, 23, 13088. https://doi.org/10.3390/ijms232113088
Cavalu S, Elbaramawi SS, Eissa AG, Radwan MF, S. Ibrahim T, Khafagy E-S, Lopes BS, Ali MAM, Hegazy WAH, Elfaky MA. Characterization of the Anti-Biofilm and Anti-Quorum Sensing Activities of the β-Adrenoreceptor Antagonist Atenolol against Gram-Negative Bacterial Pathogens. International Journal of Molecular Sciences. 2022; 23(21):13088. https://doi.org/10.3390/ijms232113088
Chicago/Turabian StyleCavalu, Simona, Samar S. Elbaramawi, Ahmed G. Eissa, Mohamed F. Radwan, Tarek S. Ibrahim, El-Sayed Khafagy, Bruno Silvester Lopes, Mohamed A. M. Ali, Wael A. H. Hegazy, and Mahmoud A. Elfaky. 2022. "Characterization of the Anti-Biofilm and Anti-Quorum Sensing Activities of the β-Adrenoreceptor Antagonist Atenolol against Gram-Negative Bacterial Pathogens" International Journal of Molecular Sciences 23, no. 21: 13088. https://doi.org/10.3390/ijms232113088
APA StyleCavalu, S., Elbaramawi, S. S., Eissa, A. G., Radwan, M. F., S. Ibrahim, T., Khafagy, E.-S., Lopes, B. S., Ali, M. A. M., Hegazy, W. A. H., & Elfaky, M. A. (2022). Characterization of the Anti-Biofilm and Anti-Quorum Sensing Activities of the β-Adrenoreceptor Antagonist Atenolol against Gram-Negative Bacterial Pathogens. International Journal of Molecular Sciences, 23(21), 13088. https://doi.org/10.3390/ijms232113088

